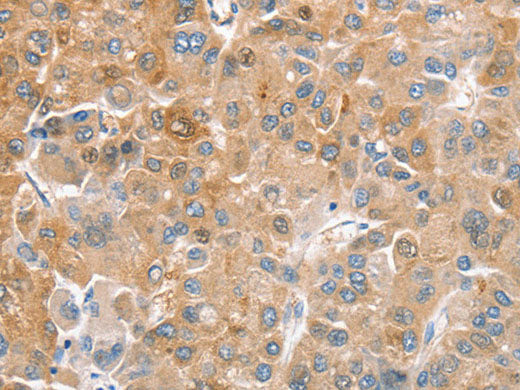
CDR2 Polyclonal Antibody

CDR2 Polyclonal Antibody
Couldn't load pickup availability

Still have questions? Ask our experts!
CDR2 Polyclonal Antibody
| SKU # | E-AB-11068 |
| Reactivity | Human, Mouse |
| Host | Rabbit |
| Applications | IHC |
Product Details
| Isotype | IgG |
| Host | Rabbit |
| Reactivity | Human, Mouse |
| Applications | IHC |
| Clonality | Polyclonal |
| Immunogen | Recombinant protein of human CDR2 |
| Abbre | CDR2 |
| Synonyms | AA617262, CDR 2, CDR 62, CDR2, CDR62, Cerebellar degeneration related protein, Cerebellar degeneration related protein 2, Cerebellar degeneration related protein 2 62kDa, Cerebellar degeneration-related protein 2, MGC, MGC116181, Major Yo paraneoplastic antigen |
| Swissprot | |
| Cellular Localization | Other locations: cytoplasm. |
| Concentration | 0.4 mg/mL |
| Buffer | Phosphate buffered solution, pH 7.4, containing 0.05% stabilizer and 50% glycerol. |
| Purification Method | Affinity purification |
| Research Areas | Cancer, Immunology |
| Conjugation | Unconjugated |
| Storage | Store at -20°C Valid for 12 months. Avoid freeze / thaw cycles. |
| Shipping | The product is shipped with ice pack,upon receipt,store it immediately at the temperature recommended. |
Related Reagents
| Applications | Recommended Dilution |
| IHC | 1:50-1:200 |
Background
CDR2 (cerebellar degeneration-related protein 2), also referred to as Yo or CDR62, is a 545 amino acid protein that is associated with the development of paraneoplastic cerebellar degeneration (PCD).PCD, an immune-mediated syndrome, belongs to a heterogeneous group of rare paraneoplastic neurologic disorders affecting the neurological system.PCD is characterized by subacute cerebellar ataxia and occurs mainly in patients with ovarian, uterine, fallopian tube or breast cancer.